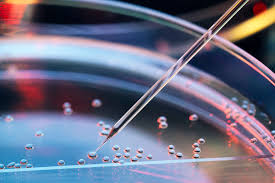

Gene therapy has been successfully used to regenerate damaged nerve fibers in the eye and this may lead to the development of glaucoma treatments.

Nerve fibers, which are known as axons, do not normally regenerate after sustaining injury or disease and in a lot of cases, damage that has been done is irreversible. Recent research, however, has offered hope that stimulating regeneration of nerve cells is possible.
A study in Nature Communications details the research that involved a protein known as Protrudin. Researchers used a gene therapy technique to increase the amount of Protrudin in the eye and optic nerve. The team then checked on the amount of regeneration to the crushed optic nerve and found that Protrudin had caused the axons to regenerate over large distances and also discovered that retinal ganglion cells were protected from cell death.
The research team then demonstrated that the technique could help protect against glaucoma by removing the retina from a mouse eye and growing it in a cell-culture dish. Usually removing the retina would cause the retinal neurons to die within three days but activating the Protrudin led to almost complete protection of the retinal neurons.
Researchers note that further research is needed to possibly find a way of protecting the retinal neurons from death and to stimulate their axons to regenerate.